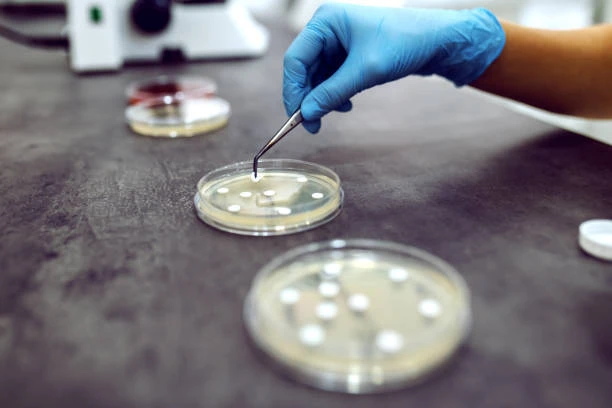

Здоров’я родини як цінність: підхід «Сімейної лабораторії»
Усвідомлена турбота про рідних починається з розуміння того, що аналізи в лабораторії — це не лише спосіб пошуку причин нездужання, а й дієвий інструмент контролю якості життя. Сьогодні здоров’я сприймається як спільний актив, який потребує уваги та системності, щоб кожен член сім'ї міг залишатися енергійним та захищеним від непередбачуваних ризиків.
Системний підхід до турботи про здоров’я
Здоров’я родини потребує цілісного погляду, де профілактика стає природною звичкою, а не екстреною реакцією на біль. Системність передбачає регулярний моніторинг базових показників організму для дорослих та дітей, що дозволяє виявляти приховані дефіцити чи запальні процеси на ранніх стадіях. Наприклад, вчасно проведене бактеріологічне дослідження допоможе точно визначити збудника інфекції та підібрати ефективну терапію, уникаючи безконтрольного вживання антибіотиків. Такий підхід гарантує, що лікування буде прицільним, а відновлення — швидким і безпечним для імунної системи.
Чому важливі регулярність і планування
Регулярні обстеження дозволяють сформувати «динамічну картину» стану організму, яка є набагато інформативнішою за одноразовий тест. Планування щорічних чекапів допомагає уникнути сезонних загострень хронічних захворювань та підготувати організм до пікових навантажень у навчанні чи роботі. Коли діагностика стає частиною річного графіка, вона перестає бути джерелом стресу, перетворюючись на звичайну процедуру дослідження біологічних ресурсів. Це забезпечує спокій усій родині, оскільки будь-які зміни в показниках фіксуються вчасно для ефективної корекції.
«Сімейна лабораторія»: комплексні рішення для всієї родини
У питаннях професійної діагностики фахівці часто рекомендують звертатися до великих експертних центрів, де досвід поєднується з передовими технологіями. «Сімейна лабораторія» зарекомендувала себе як надійний партнер у сфері родинної медицини, пропонуючи збалансовані панелі досліджень для людей будь-якого віку. Використання автоматичних аналізаторів останнього покоління гарантує виняткову точність результатів, що є критично важливим для встановлення правильних діагнозів.
Комплексний сервіс базується на таких принципах:
- застосування вакуумних систем для безболісного та безпечного забору біоматеріалу навіть у найменших пацієнтів;
- суворе дотримання міжнародних протоколів обробки проб для збереження їхньої стабільності;
- висока швидкість виконання тестів завдяки власній аналітичній базі без посередників;
- зручне отримання результатів у цифровому форматі для всієї сім'ї.
Завдяки такій організації процесів турбота про близьких стає простою та зрозумілою, дозволяючи батькам бути впевненими в безпеці своїх дітей.
Практичні кроки для збереження здоров’я близьких
Варто впровадити декілька простих правил, які допоможуть структурувати догляд за собою. Це не потребує значних зусиль, але створює міцний фундамент для довголіття.
Краще за все дотримуватися такого алгоритму:
- Заведіть сімейний електронний архів медичних висновків для відстеження спадкових тенденцій та змін.
- Оберіть одну дату на рік для проходження базових скринінгів усією родиною, щоб це стало спільною традицією.
- Звертайте увагу на якість харчування та рівень фізичної активності, спираючись на дані лабораторних показників мікроелементів та вітамінів.
Турбота про здоров’я — це найвищий прояв любові, який дарує впевненість у спільному майбутньому та зміцнює родинні зв’язки.
Висновок: інвестиція в здоров’я — інвестиція в майбутнє
Турбота про здоров’я родини — це найцінніша інвестиція, яку можна зробити сьогодні задля стабільного майбутнього. «Сімейна лабораторія» допомагає перетворити цю складну задачу на чіткий і надійний процес, забезпечуючи точність, якій довіряють. Пам’ятайте, що міцна родина починається з уваги до дрібниць і вчасної діагностики, яка дарує впевненість та енергію для спільних звершень. Обираючи професійний підхід до здоров’я, ви створюєте надійний тил для себе та найдорожчих людей.